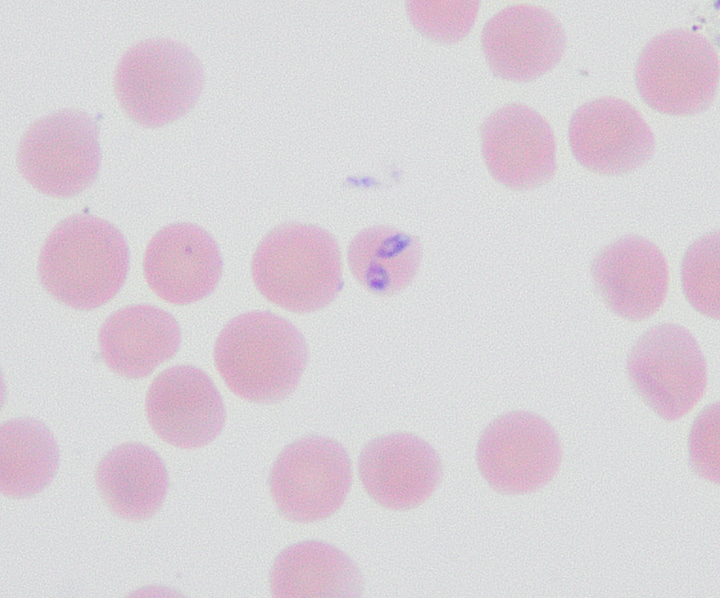
Left: B. theileri spirochete; Right: RBC in center contains two Babesia piroplasms

Field Notes: February 2026
A (final?) locum adventure to the Caribbean
Dear Readers,
I’m currently writing this in the cool AC of Rituals Coffee House overlooking Frigate Bay on St. Kitts. For the past week, and the next two, I have been teaching 2nd year vet students at Ross University about the kidneys, electrolytes, and acid-base physiology and testing. This is my second locum block here after last summer and both times have been a blast. In a world where we constantly hear about how college students are struggling to read and using AI to cheat, that has not been my experience here at all. In fact, the students are whip-smart and keep me on my toes with thoughtful questions that challenge my own assumptions. It’s definitely true what they say:
“You don’t truly understand a subject until you can teach it”
Another component of the job is some light diagnostic work. Practicing in a place that is resource-constrained is a great reality check about spectrum-of-care for someone used to recommending tests that cost hundreds or thousands of dollars. It’s also a great opportunity to review samples with exotic diseases we don’t have in the States: a huge number of both the dogs and farm animals are either currently infected with, or previously exposed to, tropical tick borne diseases. Last July, I saw blood films from cattle with the spirochetes that cause relapsing fever (Borrelia theileri) and the parasite Babesia bovis. Neither is endemic in the US, primarily causing disease in Africa, Australia, South America, parts of southeast Asia, and of course, the Caribbean.
(Pro-tip for vet students: Bovine babesiosis is a reportable disease in the US!)1

Outside of work, it’s a lot of fun to explore both St. Kitts and her sister island Nevis, which together form one sovereign nation. The scenic coastline is split evenly between the Atlantic Ocean and the Caribbean Sea, and the two halves have very different vibes. You can actually see both sides at once from Timothy Hill, the iconic tourist photo spot featured at the top of this post. The island has a laid back vibe and you can enjoy delicious seafood and ice cold Carib beers all over. Two can’t miss spots are the beach bar Ship Wreck and the famous Sprat Net.
Another must-see attraction on the island is hiking Mt. Liamuiga, aka Mount Misery (seriously!) While the view from the summit is breathtaking, it is a very strenuous climb that is not without risk. I wrote about my solo trek to the top, and what it reminded me about resilience, in this essay:
Climbing the Mountain
"This might have been a mistake, I thought as I tripped and slipped backwards downhill several yards, scraping my ankle on a rock. The gash was oozing a small amount of blood and covered in mud. I was about 2,000 feet above sea level and over an hour into my hike up Mount Liamuiga. It was too late to turn back now. The only way out was through."
I’ve included a few highlights from St. Kitts in the photo gallery below. On a final personal note, I will have some exciting career news to share in the coming months! Stay tuned… 👀









What I’m Reading
I usually spend most editions of “Field Notes” writing about a handful of different medical and research topics. With my packed travel and teaching schedule, I had less time to put together a full round-up. So in its place, here are a few things worth sharing:
Surge in rabies reports prompts public health concerns — This story by VIN News reports on the rise in rabies infections in wildlife in many states (OR, NC, NY, SC, and VT), along with an atypical case of rabies in a dog in Chicago
Autoimmune lymphoproliferative syndrome (ALPS) in dogs — This is a blockbuster two-part case report in the Journal of Veterinary Internal Medicine about a week ago. It describes a never-before-seen genetic syndrome that mimics lymphoma in a litter of puppies (don’t worry: they recovered with immunosuppressive drugs 😊)
Epidemiology of four major canine tumors in the UK — This is a massive study (>130,000 cases) of the breed risks and other characteristics for mast cell tumor, osteosarcoma, hemangiosarcoma, and melanoma. This impressive work was the result of collaboration between private practices and universities analyzing the Small Animal Veterinary Surveillance Network (SAVSNET) tumor registry
New study shows ChatGPT Health failed to identify medical emergencies — It inappropriately triaged over half of true emergencies, and in some situations failed to recognize obvious suicidal ideation 😬 This is a scary reminder that Large Language Model (LLM) AI is very-much not ready for prime-time, at least when it comes to consumer-facing health applications.
Mississippi health system shuts down clinics statewide after ransomware attack — Finally, this story from NPR on a cyberattack crippling the largest health system in Mississippi is literally a plotline on season 2 of The Pitt. Sometimes life imitates art!
Alright, that’s it for this edition of Field Notes. Stayed tuned for more focused articles in the coming weeks!
—Eric
I spend most of my time thinking about crazy internal medicine and oncology diseases in pets, but it’s worth remembering that vetmed plays an important public health role in keeping our food supply safe







Glad to see you’re enjoying your time down there.